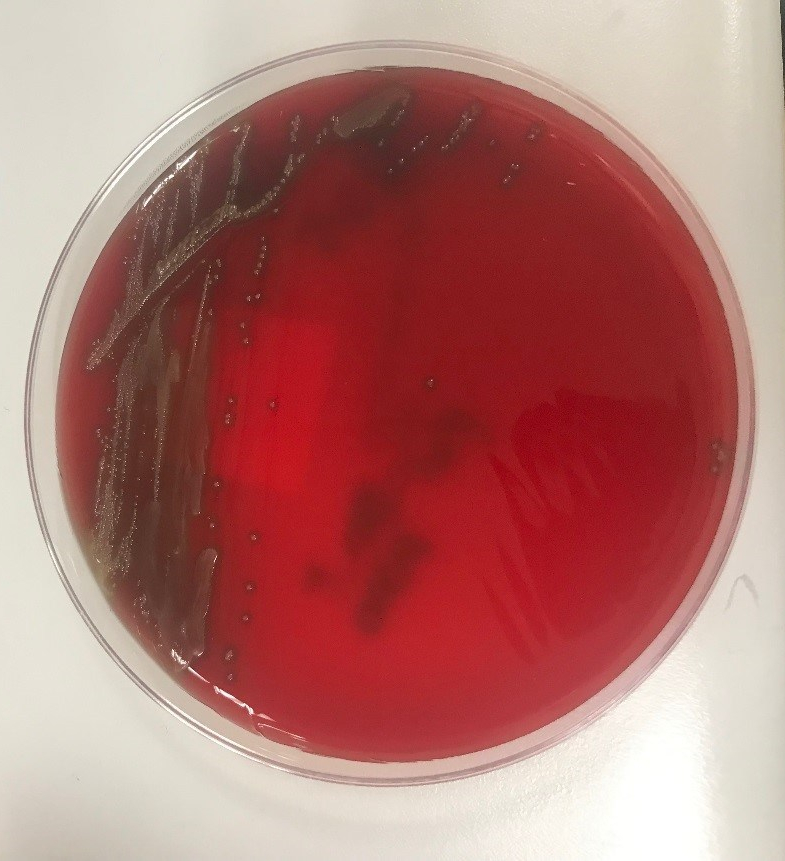

Clinical History
A 75 year old female with a past medical history of breast cancer presented to the Emergency Department with chills 3 weeks status-post bilateral breast reconstruction due to ruptured silicone breast implants. Her white blood cell count was 13,440/cmm and her temperature was 39.4ºC. Physical examination revealed erythema of the right breast incision and purulent drainage from the Jackson-Pratt (JP) drain. Two blood cultures were drawn and a specimen was collected from the JP drain fluid and sent for gram smear and culture.
Laboratory Findings
Blood cultures were negative for growth. Gram stain of the drain fluid was significant for many polymophonuclear neutrophils, however no bacteria were seen. Aerobic cultures grew gram positive cocci. Matrix assisted laser desorption ionization-time of flight mass spectrometry (MALDI-TOF) analysis identified Streptococcus gordonii. The patient was started on doxycycline and amoxicillin-clavulanate. Antibiotic susceptibility testing subsequently showed susceptibility to ceftriaxone and penicillin.

Discussion
Streptococcus gordonii is a gram positive, non-motile, facultative anaerobic cocci that is part of the Streptococcus sanguinis group of viridans group streptococci (VGS). It is a common oral bacteria that has been implicated in invasive infections such as endocarditis and septic arthritis. It is less frequently a cause of soft-tissue infections such as orbital cellulitis, osteomyelitis, and subcutaneous abscesses. There are case reports of joint prosthesis infections, however breast implant infections have not been reported. Breast implant infections are most commonly caused by Staphylococcus aureus, Pseudomonas aeruginosa, and Staphylococcus epidermidis. There are reports of different VGS species causing breast implant infections. As the bacteria primarily resides in the mouth, infections are usually caused by oral trauma. Although symptoms may often be minor, in cases caused by VGS, systemic symptoms can occur including a toxic shock-like syndrome. In these cases there is a case fatality rate as high as 80%. S. gordonii has been reported as susceptible to clindamycin, ceftriaxone, erythromycin, and levofloxacin. Prompt treatment is important to prevent progression to systemic illness and mortality.
References
- Seng P, Bayle, S, Alliez, A, et al. The microbial epidemiology of breast implant infections in a regional referral centre for plastic and reconstructive surgery in the south of France. Int J Infect Dis. June 2015;35:62-66.
- Fenelon C, Galbraith JG, Dalton DM, Masterson E. Streptococcus gordonii—a rare cause of prosthetic joint infection in a total hip replacement. J Surg Case Rep. 2017 Jan;1:235.
- Liao CY, Su KJ, Lin CH, et al. Planta purpura as the initial presentation of viridans streptococcal shock syndrome secondary to Streptococcus gordonii bacteremia. Can J Infect Dis Med Microbiol. 2016:946385.
- Dadon Z, Cohen A, Szterenlicht YM, et al. Spondylodiskitis and endocarditis due to Streptococcus gordonii. Ann Clin Microbiol Antimicrob. 2017:16:68.
- Krantz AM, Ratnaraj F, Velagapudi M et al. Streptococcus gordonii empyema: a case report and review of empyema. Cureus. 2017 Apr;9(4):e1159.
-Jonathan Wilcock, MD is a 1st year anatomic and clinical pathology resident at the University of Vermont Medical Center.

-Christi Wojewoda, MD, is the Director of Clinical Microbiology at the University of Vermont Medical Center and an Associate Professor at the University of Vermont.